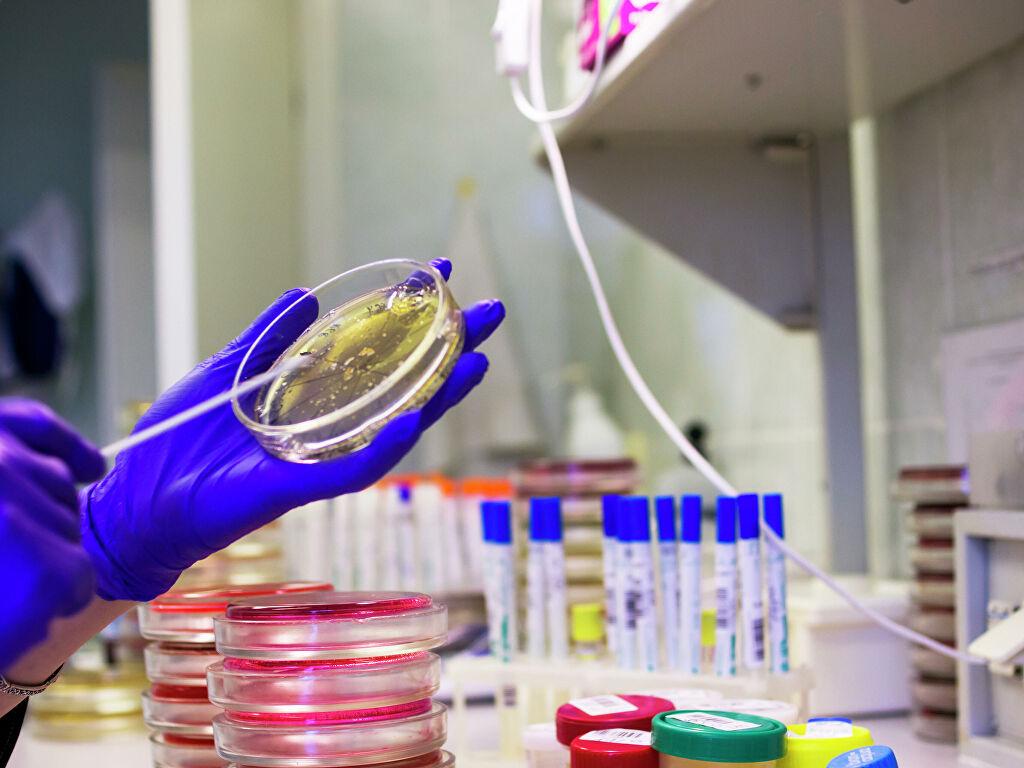

В Литве – дискуссии о страховании и пособиях для безработных
Министр социальной защиты и труда Литвы заявляет, что официально зарегистрированные безработные не должны автоматически получать государственное обязательное медицинское страхование. По словам Моники Навицкене, подобную практику нужно менять. Правда, позже министр уточнила свою позицию в Facebook.